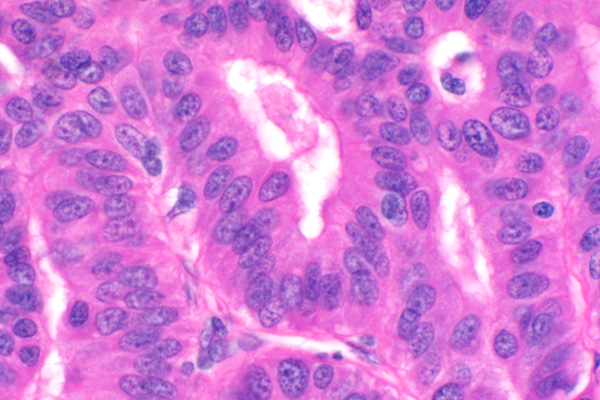

| 40x | Hematoxylin and Eosin | ||||
| Close Window | Macro View | Back | ||
|
Crowded columnar cells have oval, basally oriented nuclei with finely stippled chromatin. The lumena of tubuloacini contain secretory product or sloughed cells.
|
||||
|
|
||||
| Return | ||||
|
Crowded columnar cells have oval, basally oriented nuclei with finely stippled chromatin. The lumena of tubuloacini contain secretory product or sloughed cells.
|
||||